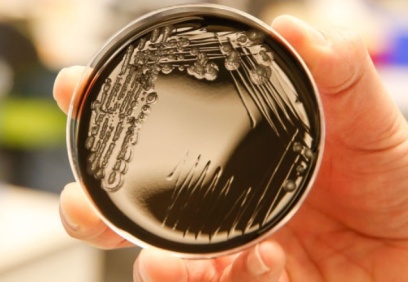
Bakteriler, gezegenler arasında yolculuk yapıyormuş

Yaşam
Bakteriler, gezegenler arasında yolculuk yapıyormuş
Japon bilim insanlarının Uluslararası Uzay İstasyonu’nun dış yüzeyinde yaptığı araştırma, bakterilerin uzayda yıllarca hayatta kalabildiğini ortaya koydu. Araştırmacılar, bu keşfin uzaydaki yaşam formlarının gezegenler arasında yer değiştirebileceğini gösterdiği görüşünde.
26 Ağustos 2020

Dünya, 33 bin yıldır devasa radyoaktif bulutun içinden geçiyor
Bilim insanlarının iki farklı bölgeden aldığı 33 bin yıllık derin deniz tortulları üzerinde yapılan araştırmada, tortullarda demir-60 izotopunun açık izleri keşfedildi.
26 Ağustos 2020

Yarkadaş: Kilis'te bir cinsel saldırı faili serbest bırakıldı
CHP eski Milletvekili Barış Yarkadaş, sosyal medya hesabından yaptığı paylaşımlarla Kilis'te de bir cinsel saldırı failinin serbest bırakıldığını belirtti.
26 Ağustos 2020

Dr. Esra E. Bilgiç: "Pandemide ekran süresindeki artış yüzde 500"
Pandemide çocukların ekran başında geçirdiği süre arttı, bu süreçte siber zorbalık vakalarında da artış gözlendi. Bilgi Üniversitesi öğretim üyesi Bilgiç, yapılan araştır...
25 Ağustos 2020

CHP Milletvekili Mahmut Tanal: "Çocuk işçiliğiyle mücadele edilmiyor, reklam yapılıyor"
Uluslararası kuruşların denetimindeki METİP'lerde kalan işçi çocukları ziyaret ettiklerini belirten Tanal, "Muhalefetin programı sorulmadan, MHP ve Ak Parti dayatmasıyla...
25 Ağustos 2020





























